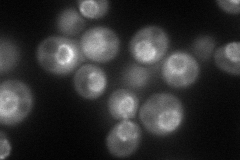
YER107C
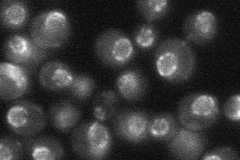
YER107C
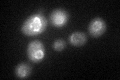
YER107C

View description
Component of the Nup82 subcomplex of the nuclear pore complex; required for polyadenylated RNA export but not for protein import; homologous to S. pombe Rae1p
Localization:
Intensity:
Fold change:
Significance:
-
C’ GFP library in SD

nuclear periphery30.15 -
N' NOP1pr-GFP in SD
punctate,nuclear periphery112.803 -
N' TEF2pr-mCherry in SD

punctate,nuclear periphery59.8785 -
N' NATIVEpr-GFP in SD
punctate,nuclear periphery37.3398 -
N' TEF2pr-VC and Cyto-VN in SD

nuclear periphery33.1409 -
C’ GFP library in SD+DTT
nuclear periphery24.920.82No -
C’ GFP library in SD+H2O2

nuclear periphery25.920.85No -
C’ GFP library in Starvation Media

nuclear periphery34.251.13No -
C’ GFP library on the background of Pup2-DaMP

nuclear periphery -
C’ GFP library on the background of CCT mutant

nuclear periphery22.11340.733209No
